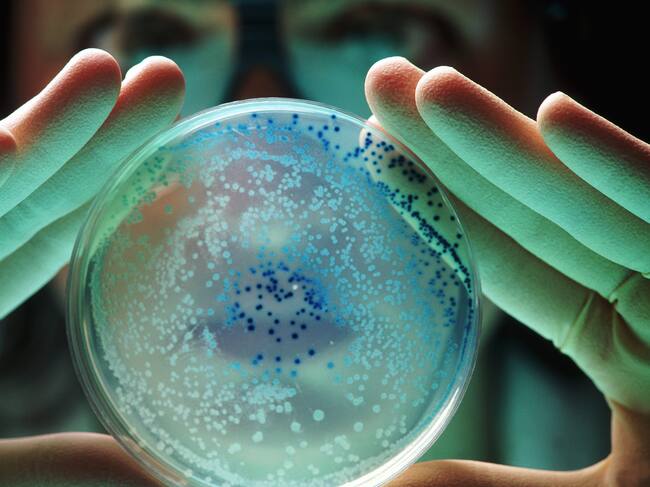

Estudio revela que las bacterias son capaces de “almacenar recuerdos”
Investigadores de la Universidad de Texas, en conjunto con un equipo de Delaware, lograron comprobar que el E. Coli es capaz de almacenar recuerdos sobre factores ambientales y transmitirlos hasta 7 generaciones futuras
Imagen de referencia de bacterias / Getty Images

La bacteria sobre la cual se centró el estudio fue la Escherichia coli (E.coli), un organismo que suele estar presente en todo el planeta, especialmente en los intestinos de las personas y los animales. La mayoría de las variantes de esta bacteria no suponen mayor peligro, sin embargo, su facilidad para expandirse ha ocasionado que durante años esté en el centro de las investigaciones.
Para la investigación expusieron a las bacterias a un ambiente con hierro, los investigadores evidenciaron que las primeras generaciones de bacterias actuaban de forma instintiva y natural frente al ambiente hostil. Sin embargo, las generaciones posteriores se desenvuelven de formas mucho más eficientes.
Se eligió el hierro como material puesto que este es uno de los más abundantes en todo el planeta Tierra, algo que favorece las investigaciones posteriores.
“Las bacterias no tienen cerebro, pero pueden recoger información de su entorno y, si se han encontrado con ese entorno con frecuencia, pueden almacenar esa información y acceder a ella rápidamente”, explicó uno de los autores principales de la investigación, Souvik Bhattacharyya.
Aunque no se ha esclarecido del todo si lo que producen es una “Memoria” o “recuerdos” si se demostró que su comportamiento se asemeja mucho a la manera en que los seres humanos almacenamos recuerdos.
El estudio demostró algo realmente intrigante, pues como es bien sabido las bacterias no tienen neuronas ni mucho menos sistema nervioso por lo que la forma en la que “almacenan” recuerdos es todo un misterio. Se busca que las investigaciones posteriores descifren los mecanismos de estas acciones.
El estudio mencionado fue publicado en la revista científica PNAS y el descubrimiento puede producir en el futuro diversas aplicaciones que ayudarían a combatir las infecciones que producen estas bacterias en los seres vivos.
¿Conoce el secreto para vivir hasta los 100 años? Virus y bacterias parecen tener la respuesta
Pasando a otros temas, también se conoció un estudio, publicado en ‘Nature Micriobiology’, donde los investigadores estudiaron a 176 centenarios japoneses sanos y descubrieron que estos presentaban dicha combinación, que podría teneruna gran influencia en su larga vida.
“Siempre estamos ansiosos por descubrir por qué algunas personas viven vidas extremadamente largas. Investigaciones anteriores han demostrado que las bacterias intestinales de los ciudadanos japoneses de edad avanzada producen moléculas completamente nuevas que los hacen resistentes a los microorganismos patógenos, es decir, promotores de enfermedades”, explicó el autor del estudio, Joachim Johansen.
Por este motivo, el investigador aseguró que “si sus intestinos están mejor protegidos contra las infecciones, eso es probablemente una de las cosas que hacen que vivan más que otros”. Los investigadores también encontraron que la flora intestinal de los japoneses centenarios es extremadamente interesante.
“Encontramos una gran diversidad biológica tanto en bacterias como en virus bacterianos en los centenarios. La alta diversidad microbiana generalmente se asocia con un microbioma intestinal saludable. Y esperamos que las personas estén mejor protegidas contra las enfermedades relacionadas con el envejecimiento”, dice Joachim Johansen.
Entre otras cosas, el nuevo estudio muestra qué virus específicos en los intestinos pueden tener un efecto beneficioso sobre la flora intestinal y, por lo tanto, sobre la salud.




